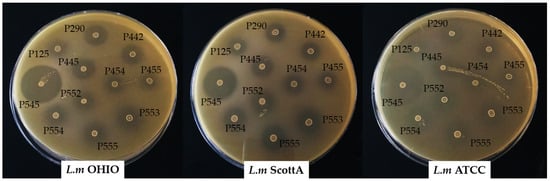

Abstract
Enterocins are bacteriocins synthesized by Enterococcus strains that show an interesting antimicrobial effectiveness against foodborne pathogens such as Listeria monocytogenes. The objectives of this study were to identify and analyze the expression of enterocin genes of Enterococcus isolated from breast-fed infants and evaluate their ability to inhibit three human isolates of virulent L. monocytogenes, as well as some probiotic bacteria. The susceptibility of the strains of L. monocytogenes to fifteen antibiotics was tested, detecting their resistance to cefoxitin (constitutively resistant), oxacillin, and clindamycin. The production of enterocins A, B, and P was observed in Enterococcus faecium isolates, while enterocin AS-48 was detected in an Enterococcus faecalis isolate. AS-48 showed antilisterial activity by itself, while the joint action of enterocins A and B or B and P was necessary for inhibiting L. monocytogenes, demonstrating the synergistic effect of those combinations. The presence of multiple enterocin genes does not assure the inhibition of L. monocytogenes strains. However, the expression of multiple enterocin genes showed a good correlation with the inhibition capacity of these strains. Furthermore, the potential beneficial strains of lactobacilli and bifidobacteria examined were not inhibited by any of the enterocins produced individually or in combination, with the exception of Bifidobacterium longum BB536, which was inhibited by enterocin AS-48 and the joint production of enterocins A and B or B and P. The enterocins studied here could be candidates for developing alternative treatments against antibiotic-resistant bacterial infections. Moreover, these selected enterocin-producing E. faecium strains isolated from breast-fed infants could be used as probiotic strains due to their antilisterial effect, as well as the absence of virulence factors.
1. Introduction
The current worldwide increase in resistant bacteria has led to a search for novel antimicrobial agents. Within this scenario, bacteriocins and bacteriocin-like inhibitory compounds produced by lactic acid bacteria are promising tools against pathogenic bacteria due to the fact that they have been used safely for many years, and thanks to their stability in a wide range of physicochemical conditions, their mechanisms of action (which are different from the commonly used therapeutic products), and their ability to influence the host immune responses (acting as signaling peptides). Moreover, they can be subjected to gene-based peptide engineering [1].
Listeria monocytogenes causes listeriosis and is predominantly foodborne, particularly in ready-to-eat food. It most often affects vulnerable population groups, such as pregnant women, newborn infants, children, immunocompromised subjects, and the elderly. However, human listeriosis cannot always be attributed to the consumption of contaminated food products, having several potential methods of transmission, including neonatal cross-infection [2]. Antibiotics are the most common treatment choice for listeriosis, although antibiotic resistance in L. monocytogenes has been reported over the past few decades [3]. Listeriosis is an emerging infection representing a public health concern worldwide and has a high incidence in pregnant women [4,5,6,7,8,9]. Infection during pregnancy can cause fetal loss, premature birth, and illness or death in newborns [10].
Enterococcus spp. have been isolated from different environments and are indigenous inhabitants of the healthy human gastrointestinal tract. Some of them are able to produce ribosomally synthesized antimicrobial peptides or bacteriocins called enterocins. They are considered one of the most significant bacteriocin producers, both in number of bacteriocin-producing isolates and variety [11]. Enterocins are peptides secreted extracellularly during the metabolic process. Enterocins can be categorized into four major classes: Class I, known as lantibiotic enterocins; Class II, composed of small heat-stable, non-lantibiotic enterocins; Class III, or cyclic enterocins; and Class IV, which includes large peptides linked to lipids or carbohydrates. The increasing interest in bacteriocins produced by LAB has been enhanced by their spectrum of activity, being able to inhibit Gram-positive pathogens such as L. monocytogenes, Staphylococcus aureus, Bacillus cereus, or Clostridium botulinum [12]. Enterococcus faecalis and Enterococcus faecium are the species most commonly found in the human gut [13]. Due to their function in supporting well-being and health as part of the intestinal microbiota, the development of strains of enterococci as probiotics with beneficial effects on the health of the host has gained increasing interest [14]. However, the use of enterococci as a probiotic is controversial due to their role as opportunistic pathogens outside of the gastrointestinal tract [15]. Some studies suggest that cases of nosocomial infections by the genus only occur in vulnerable populations, including hospitalized children, and are caused by enterococci that contain virulence factors, especially vancomycin-resistant enterococci [16].
Breast-feeding can be a considerable source of enterococci for the nursing infant’s gut [17] and may have an influence on the overall composition of the microbiota and, therefore, on its physiological functions. In a previous work from our group, a total of 41 enterococci (26 E. faecalis and 15 E. faecium) were isolated from healthy breast-fed infants younger than 6 months, and the presence of virulence factors, antibiotic resistances, and biogenic amine production was evaluated [18]. Here, the evaluation of enterocin production by those enterococci was carried out, which can be of interest as alternatives to antibiotics due to the increase in the number of resistances both in clinical and commensal bacteria [19,20,21]. Several studies have been published in recent decades reporting that bacteriocins may be used as alternatives to antibiotics in the prophylaxis or treatment of bacterial infections, including those caused by multidrug-resistant (MDR) strains [22]. The use of bacteriocins as therapeutic agents, and as part of a multiple-hurdle approach with antibiotics, has been explored as a viable alternative that could also reduce the undesirable effects of antibiotics on the intestinal microbiota during the treatment of intestinal infections [23,24]. Moreover, the fact that Enterococcus strains have been isolated from infant feces could be an advantage over other strains isolated from foods [25,26] for their potential use as probiotics [11,27], since they would be able to compete with pathogenic bacteria for nutrients and establish the gastrointestinal tract [28].
The aim of this study was to analyze the occurrence of bacteriocin activity among enterococci isolated from breast-fed infants and their activity against virulent L. monocytogenes and beneficial bacteria. Additionally, purified or partially purified enterocins, as well as bacteriocinogenic enterococci strains, as alternative treatments against antibiotic-resistant L. monocytogenes infections were discussed.
2. Materials and Methods
2.1. Bacterial Cultures and Media
A total of 26 E. faecalis and 15 E. faecium isolates from fecal samples from 23 healthy breast-fed infants younger than 6 months were used in this study [18]. Isolates were cultured in MRS broth (Scharlau Chemie SA, Barcelona, Spain) at 37 °C in aerobic conditions.
L. monocytogenes strains were grown in TSB (Scharlau Chemie SA, Barcelona, Spain) at 37 °C in aerobic conditions. Lactobacilli strains were grown in MRS at 37 °C in aerobic conditions, whereas Bifodobacterium strains were grown in RCM broth (BD, Le Pont de Claix, Grenoble, France) at 37 °C in anaerobic conditions in sealed jars using AnaeroGen sachets (Oxoid, Ltd., Basingstoke, UK).
2.2. L. monocytogenes Antibiotic Susceptibility Testing
Antimicrobial susceptibility testing of the human isolates of virulent L. monocytogenes was performed on Müller–Hinton agar (Condalab, Madrid, Spain) supplemented with 5% defibrinated horse blood (Thermo-Fisher Scientific, Waltham, MA, USA) and 20 mg/mL β-NAD (Sigma-Aldrich, St. Louis, MO, USA) according to the disk diffusion method recommended by the European Committee on Antimicrobial Susceptibility Testing (EUCAST, Basel, Switzerland) [29]. The following antibiotics, chosen for using in the veterinary and human medicine for treatment of listeriosis, were tested: penicillin G (10 IU/disc), ampicillin (10 µg/disc), amoxicillin/clavulanic acid (30 µg/disc), oxacillin (1 µg/disc), gentamicin (10 µg/disc), chloramphenicol (30 µg/disc), vancomycin (30 µg/disc), tetracyclin (30 µg/disc), ciprofloxacin (5 µg/disc), clindamycin (2 µg/disc), erythromycin (15 µg/disc), cefoxitin (30 µg/disc), trimethoprim-sulphamethoxazole (25 µg/disc), meropenem (10 µg/disc), and rifampicin (5 µg/disc) (Oxoid). The control strain used in this study was Staphylococcus aureus ATCC 29213.
2.3. Detection of Enterocin Genes
Enterocin-encoding genes in the enterococci above mentioned were detected by PCR using the specific oligonucleotide primers listed in Table 1. The PCR were sequenced and compared with known sequences in the BLASTN database (National Center for Biotechnology Information—NCBI, Bethesda, MD, USA).

Table 1.
Primers used in this study for enterocin-encoding gene detection.
2.4. Bacteriocin Bioassay and Spectrum of Activity
The antimicrobial activity of enterococcal strains harboring enterocin genes was tested using L. monocytogenes Scott A, L. monocytogenes OHIO, and L. monocytogenes ATCC 19115 as indicator strains. Enterocin extracts were obtained by centrifuging at 10,000× g for 15 min at 4 °C an 18 h culture of the enterocin producer, followed by filtering the supernatant through a 0.22 mm pore size low protein binding filter (Millex GV, Millipore, Molsheim, France), and raising the pH to 6.5 with 2 M NaOH. Enterocin extracts were aliquoted and stored at −70 °C until use. Bacteriocin activities were evaluated using a microtiter plate assay as described by Holo et al. (1991) [37]. After aerobic incubation at 37 °C for 24 h, the growth of indicator strains was examined. The titer (expressed in enterocin units [EU] per milliliter) was defined as the reciprocal of the highest dilution that did not allow the growth of the indicator strain. Two independent trials were performed and each strain was assayed in duplicate.
Later, enterocin assays were also carried out against Lacticaseibacillus rhamnosus GG, Limosilactobacillus reuteri Biogaia, Limosilactobacillus reuteri INIA P572, Lacticaseibacillus paracasei INIA P272, Lacticaseibacillus rhamnosus INIA P344, Bifidobacterium longum BB536, Bifidobacterium animalis BB12, Bifidobacterium pseudolongum INIA P2, and Bifidobacterium breve INIA P18. Plates of MRS, RCM, or TSA were used for the different strains.
2.5. Total RNA Isolation and Reverse Transcription (RT)-PCR Analysis
The Enterococcus that harbor enterocin genes were grown in MRS broth (10 mL) overnight under aerobic conditions at 37 °C. The total RNA was isolated using the High Pure RNA isolation kit (Roche, Mannheim, Germany) as specified by the manufacturer. The RNA was quantified by measuring its optical density at 260 nm. The total RNA quality was assessed spectrophotometrically and with gel electrophoresis. Using a GeneAmpR EZ rTth RNA PCR kit (Applied Biosystems, Branchburg, NJ, USA) according to the manufacturer’s instructions, the total RNA was then used as a template to generate first-strand cDNA for PCR amplification. The RNA and cDNA samples obtained above were used for the PCR amplification of the enterocin A, enterocin B, and enterocin P genes with the oligonucleotides listed in Table 1. The constitutively expressed 16S rRNA (63F/1387R) served as an internal control gene for these RT-PCR experiments.
The following PCR conditions were used: denaturation at 95 °C for 5 min; 35 cycles of denaturation at 94 °C for 15 s, annealing at 57 °C for 30 s, and extension at 72 °C for 60 s; and a final extension cycle at 72 °C for 5 min. The amplification products were resolved by electrophoresis in 2% agarose gels. To confirm the absence of contaminating DNA, similar experiments were conducted without reverse transcriptase.
2.6. Overlay Agar Spot Assay
Enterococcus strains with enterocin genes were grown overnight in MRS broth (Condalab) at 37 °C under aerobic conditions. Two microliters of inoculums was spot inoculated onto the MRS agar plates and grown for 18 h at 37 °C under aerobic conditions. The MRS agar plates containing the growth of Enterococcus strains in spot form were then overlaid with 0.75% brain–heart infusion agar (Condalab) inoculated with 106 log cfu/mL of the different L. monocytogenes strains, and incubated at 37 °C for 24 h. Two independent trials were performed and each pathogenic strain was assayed in duplicate. The diameter of inhibition were measured and expressed in mm as the mean of n = 4.
3. Results
3.1. Antibiotic Susceptibility of L. monocytogenes
Zones of inhibition were measured in opened plates and with reflected light and were interpreted according the EUCAST criteria. The breakpoints of Staphylococcus spp. resistance were considered if no resistance criteria exist in the EUCAST or Clinical and Laboratory Standards Institute (CLSI) guidelines for Listeria susceptibility testing. Based on the results, the strains were classified as sensitive, intermediate resistant, or resistant.
Fifteen antibiotics belonging to penicillins, aminoglycosides, phenicols, glycopeptides, tetracyclines, fluoroquinolones, lincosamides, macrolides, cephalosporins, sulfonamides, and carbapenems were tested. The three strains of virulent L. monocytogenes were sensitive to most antibiotics tested, specifically to penicillins (penicillin G, ampicillin, and amoxicillin/clavulanic acid), aminoglycosides (gentamycin), phenicols (chloramphenicol), glycopeptides (vancomycin), tetracyclines (tetracycline), fluoroquinolones (ciprofloxacin), macrolides (erythromycin), sulfonamides (trimethoprim-sulphamethoxazole), carbapenems (meropenem), and rifamycins (rifampicin), with inhibition halos between 23 mm and 39 mm (Figure 1 shows the inhibition halos corresponding to erythromycin as an example of sensitivity to the antibiotic concentrations studied).

Figure 1.
Antibiotic susceptibility testing of L.m OHIO, L. monocytogenes OHIO; L.m ScottA, L. monocytogenes Scott A; L.m ATCC, L. monocytogenes ATCC 19115 by the disk diffusion method. Erythromycin (15 µg/disc); oxacillin (1 µg/disc); clindamycin (2 µg/disc); and cefoxitin (30 µg/disc).
The three strains studied exhibited resistance to oxacillin, with halos lower than 10 mm, and to clindamycin, with halos lower than 14 mm for L. monocytogenes Scott A and L. monocytogenes ATCC 19115, and between 18 and 19 mm (intermediate resistance) for L. monocytogenes OHIO. Moreover, L. monocytogenes showed intrinsic resistance to cephalosporin antibiotics (cefoxitin), with halos between 12 and 18 mm (Figure 1).
3.2. Detection of Enterocin Genes
A total of 41 enterococci (26 E. faecalis and 15 E. faecium) were examined for the presence of enterocin genes by means of PCR. The detected enterocins are listed in Table 2. Only E. faecalis INIA P290 showed the presence of the enterocin gene AS-48, whereas 10 out of 15 E. faecium isolates harbored one (Ent A or Ent P) or two (Ent A + Ent B or Ent P + Ent P) enterocin-encoding genes (Table 2).

Table 2.
Enterocin-encoding genes detected by PCR in enterococci isolated from breast-fed infants feces, their gene expression, and antimicrobial activity against Listeria monocytogenes. The titer (expressed in enterocin units [EU] per milliliter) was defined as the reciprocal of the highest dilution causing a clear zone of inhibition.
3.3. Antimicrobial Activity
A microtiter plate assay, using strains of L. monocytogenes as an indicator organism, showed that only E. faecalis INIA P290 (Ent AS-48), E. faecium P442 (Ent A and Ent B), E. faecium P445 (Ent A and Ent B), and E. faecium P545 (Ent B and Ent P) were able to inhibit the growth of L. monocytogenes strains. The highest EU/mL was produced by E. faecium P545 which produced enterocin B and enterocin P (Table 2).
On the other hand, L. rhamnosus LGG, L. reuteri Biogaia, L. reuteri INIA P572, Lb. paracasei INIA P272, L. rhamnosus INIA P344, Bifidobacterium animalis BB12, Bifidobacterium pseudolongum INIA P2, and Bifidobacterium breve INIA P18 did not exhibit inhibition for any of the enterocins produced individually or in combination. Only Bifidobacterium longum BB536 showed inhibition by enterocin AS-48 and the joint production of enterocins A and B or B and P.
3.4. Transcriptional Analysis of Enterocins
In some cases, enterocin genes were detected by PCR; however, we did not observe the inhibition of indicator microorganisms (Table 2), thus RT-PCR was carried out to check the expression of these genes (Figure 2).

Figure 2.
RT-PCRs were performed with total RNAs and primer sets allowing amplification of enterocin gene (lanes of RT+). To confirm the absence of contaminating DNA, similar experiments were conducted without reverse transcriptase (lanes of RT-) Control PCRs were carried out with the same primer sets and genomic DNA instead of cDNAs as template.
RT-PCR analysis showed that enterocin A and enterocin B cDNA were amplified from E. faecium INIA P442 and E. faecium INA P445, and enterocin B and enterocin P cDNA were amplified from the strain E. faecium INIA P545, the expression of B being higher in both cases. Enterocin AS-48 cDNA was amplified from the strain E. faecalis INIA P290. In all these cases, the expression of the genes was correlated with the inhibition of L. monocytogenes strains. On the other hand, E. faecium INIA P553, P554, and P555 showed the expression of enterocin P; however, they did not show the inhibition of L. monocytogenes strains, and E. faecium INIA P125 and E. faecium INIA P552 did not show expression of enterocin A nor the inhibition of L. monocytogenes strains. Finally, E. faecium INA P454 showed the expression of enterocin A, but did not show expression of enterocin B or the inhibition of any L. monocytogenes strains (Table 2 and Figure 2).
3.5. Overlay Agar Spot Assay
All enterococci assayed showed a clear inhibitory antimicrobial activity around the spot against the three strains of L. monocytogenes (Figure 3). The enterocin B and enterocin P-producing E. faecium INIA P545 showed the highest diameters of inhibition (between 32 and 37 mm). The enterocin AS-48-producing E. faecalis INIA P290 and enterocin A and B-producing strains E. faecium P442 and E. faecium P445 resulted in values between 17 and 22 mm. The enterocin P-producing strains E. faecium P553, E. faecium P554, and E. faecium P555 showed diameters of inhibition between 16 and 21 mm. The lowest measurements were obtained for the enterocin A-producing or non-enterocin-producing strains E. faecium INIA P125, E. faecium INIA P454, E. faecium INIA P455, and E. faecium INIA P552 (between 10 and 18 mm).
Figure 3.
Overlay agar spot assay carry out with Enterococcus strains that showed the presence the enterocin genes using L.m OHIO, L. monocytogenes OHIO; L.m ScottA, L. monocytogenes Scott A; and L.m ATCC, L. monocytogenes ATCC 19115 as indicator strains.
4. Discussion
Unexpectedly, L. monocytogenes isolated from food, clinical, or environmental sources maintains a high susceptibility to a wide range of antibiotics used to treat human and animal infections except cephalosporins, fosfomycin, oxacillin, and licosamides [3]. However, L. monocytogenes can acquire antibiotic resistance through different mobile genetic elements from other microorganisms [38,39]. Antibiotic-resistant and multi-resistant strains of L. monocytogenes were first isolated in the 1980s [40].
Here, resistance to oxacillin, clindamycin, and cefoxitin in human strains of virulent L. monocytogenes was reported. A high variability in the percentage of resistance to oxacillin or clindamycin for L. monocytogenes isolates has been described in the literature [3,41]. This pathogen is usually susceptible to penicillins except for oxacillin. The Listeria penicillin-binding protein PBP3 is the main target of ampicillin, and this antibiotic inhibits practically all L. mocytogenes isolates. However, PBP3 is not inhibited by cephalosporins, being considering the cause of such intrinsic resistance [42]. Whether the mechanisms of resistance to oxacillin are related to a PBP is still unknown.
L. monocytogenes can also show resistance to disinfectants and heavy metals. Benzalkonium chloride resistance is associated with the overexpression of the chromosomal efflux pump MdrL, which can also extrude some kinds of antibiotics [43]. The continued use of antibiotics in the agri-food and clinical industries may lead to an increase in antibiotic resistance in L. monocytogenes in the near future. Therefore, we have to be prepared for an increase in the prevalence of multidrug-resistant strains of L. monocytogenes capable of spreading in nature.
E. faecalis and E. faecium were the predominant species of Enterococcus strains found in breast-fed infants isolates [18]. The frequency of enterocin genes among our isolates was higher in E. faecium than in E. faecalis, which is in accordance with previous studies [44,45]. As in this study, enterocin A and enterocin B genes are generally found to be associated [44,46,47]. The coproduction of enterocins A and B may be due to the two enterocins being secreted by one set of transport proteins, which is also related to the synergistic activities between the two bacteriocins [48,49].
The antimicrobial activity against L. monocytogenes observed was dependent on the presence of single bactericin genes (AS-48) or the presence of combinations of bacteriocin genes (A and B or B and P). However, the occurrence of multiple enterocin genes does not mean that the genes were expressed and secreted at the same time, as was demonstrated in the case of E. faecium INIA P454 (Table 2). According with our data, if two enterocins were secreted in the same supernatant, their antimicrobial activity is higher, as has been previously reported [48]. As far as we know, this is the first study in which the inhibition of L. monocytogenes strains was correlated with the expression of enterocin genes under the conditions tested and not with the presence of these genes. Overlay agar spot assay data are in concordance with the results with neutralized supernatants. The highest diameter of inhibition was produced by E. faecium P545 which simultaneously produced enterocin B and enterocin P. Acid could be responsible of the inhibition observed in the non-enterocin-producing strains and of the previous absence of inhibition observed in strains able to produce enterocin P or enterocin A individually, since their activity are usually higher at a low pH [50].
Enterocins have exhibited activity against different foodborne pathogens in different studies [51,52,53,54,55]; however, there is not much information about their effect against potential beneficial bacteria. In this work, no lactobacilli was inhibited, and B. longum BB536 was the only bifidobacteria sensible to the enterocins produced by the Enterococcus isolated from breast-fed infants. The use of bacteriocins may have an advantage compared with conventional antibiotics, since they have no destructive effect on commensal bacteria [56,57]. Treatment with antibiotics is one of the most common in childhood. Although they have no apparent adverse effects, it has been reported that antibiotics can lead to changes in gut microbiota, which can have an effect in the normal maturation of the microbiota [58]. In fact, the use of antibiotics has been associated with a reduced number of bacteria considered beneficial such as the short-chain fatty acids producers Bifidobacteria and Lactobacilli. Exposure to antibiotics has been linked with several conditions (gastrointestinal, immunologic, and neurocognitive) [59]. Moreover, it is expected that given the current use of antibiotics, this problem may even increase in the future.
The bacteriocinogenic enterococci strains are potential candidates for multiple health applications for their attractive properties such as antimicrobial compounds production and potential adaptation to different environments, including the gastrointestinal tract of humans. Although the safety of enterococci is a concern that must be taken into account, they are used as starter cultures, adjunct starters, or protective cultures, as well as probiotics for therapeutic treatments, without reported adverse effects [60,61,62]. The purified or partially purified enterocins showed in this paper can be considered target specific, safe, heat-stable, and able to exert a synergistic effect with antibiotics, which are interesting features for the development of alternative treatments against antibiotic-resistant bacterial infections without any particular safety concern. In this sense, it seems clear that the coproduction of bacteriocin can help the producer strain to avoid the appearance of resistance in some target strains [63]. The use of broad-spectrum antibiotics alters the host microbiota and therefore its functional capacity, which can have negative effects such as altered metabolic activity and the selection of antibiotic-resistant organisms [58]. Exposure to broad-spectrum antibiotics is particularly unfavorable during infancy and early childhood, since the microbiota lacks diversity and stability, making it more sensitive to environmental incursions. This can be particularly important in the development and education of the host immune system [64]. The use of bacteriocins could avoid these problems because of their target cell specificity.
On the other hand, it has been shown that some Enterococcus strains could reduce the infection of L. monocytogenes [65,66,67,68]. The use of probiotic bacteria isolated from breast-fed infants represents a valuable strategy to reduce the risk of disease due to their prophylactic and therapeutic potential [69]. The potential health risk linked to enterococcal strains must be carefully evaluated prior to any application. No virulence determinants or hemolysin activity was detected in any of the E. faecium studied. The gelatinase gene, when present, was silent in E. faecium, and none of the isolates were resistant to vancomycin. These traits together with their antilisterial activity and the presence of genes linked to colonization [18] could contribute for their use as probiotics able to exert a protective effect against bacterial infections.
Author Contributions
J.M.L., R.M., E.R.-M. and J.L.A. have made a substantial, direct, and intellectual contribution to the work and approved it for publication. All authors have read and agreed to the published version of the manuscript.
Funding
This work was supported by projects RTA2017-00002-00-00 and PID2022-142329OB-C32 from the Spanish Ministry of Science and Innovation.
Institutional Review Board Statement
Not applicable. We do not need ethic approval since the E. fecalis were isolated form fecal samples in another work. We just use these isolates in this paper (which are part of our culture collection) as is indicated in M&M Section 2.1. Bacterial cultures and media Twenty-six E. faecalis and 15 E. faecium isolates from faecal samples from 23 healthy breast-fed infants younger than 6 months were used in this study [18].
Informed Consent Statement
Not applicable.
Data Availability Statement
The data presented in this study are available on request from the corresponding author.
Conflicts of Interest
The authors declare no conflicts of interest.
References
- Cotter, P.; Ross, R.; Hill, C. Bacteriocins—A viable alternative to antibiotics? Nat. Rev. Microbiol. 2013, 11, 95–105. [Google Scholar] [CrossRef] [PubMed]
- McLauchlin, J.; Amar, C.F.L.; Grant, K.A. Neonatal cross-infection due to Listeria monocytogenes. Epidemiol. Infect. 2022, 150, e77. [Google Scholar] [CrossRef]
- Olaimat, A.N.; Al-Holy, M.A.; Shahbaz, H.M.; Al-Nabulsi, A.A.; Abu Ghoush, M.H.; Osaili, T.M.; Ayyash, M.M.; Holley, R.A. Emergence of antibiotic resistance in Listeria monocytogenes isolated from food products: A comprehensive review. Compr. Rev. Food Sci. Food Saf. 2018, 17, 1277–1292. [Google Scholar] [CrossRef] [PubMed]
- Wilking, H.; Lachmann, R.; Holzer, A.; Halbedel, S.; Flieger, A.; Stark, K. Ongoing high incidence and case-fatality rates for invasive listeriosis, Germany, 2010–2019. Emerg. Infect. Dis. 2021, 27, 2485–2488. [Google Scholar] [CrossRef] [PubMed]
- Pohl, A.M.; Pouillot, R.; Bazaco, M.C.; Wolpert, B.J.; Healy, J.M.; Bruce, B.B.; Laughlin, M.E.; Hunter, J.C.; Dunn, J.R.; Hurd, S.; et al. Differences among incidence rates of invasive listeriosis in the U.S. FoodNet population by age, sex, race/ethnicity, and pregnancy status, 2008–2016. Foodborne Pathog. Dis. 2019, 16, 290–297. [Google Scholar] [CrossRef] [PubMed]
- Herrador, Z.; Gherasim, A.; Lopez-Velez, R.; Benito, A. Listeriosis in Spain based on hospitalisation records, 1997 to 2015: Need for greater awareness. Eurosurveillance 2019, 24, 1800271. [Google Scholar] [CrossRef] [PubMed]
- Li, W.; Bai, L.; Ma, X.; Zhang, X.; Li, X.; Yang, X.; Huang, J.Y.; Fanning, S.; Guo, Y. Sentinel listeriosis surveillance in selected hospitals, China, 2013–2017. Emerg. Infect. Dis. 2019, 25, 2274–2277. [Google Scholar] [CrossRef]
- Zhang, X.; Niu, Y.; Liu, Y.; Lu, Z.; Wang, D.; Cui, X.; Chen, Q.; Ma, X. Isolation and characterization of clinical Listeria monocytogenes in Beijing, China, 2014–2016. Front. Microbiol. 2019, 10, 981. [Google Scholar] [CrossRef]
- Ke, Y.; Ye, L.; Zhu, P.; Sun, Y.; Zhu, Z. Listeriosis during pregnancy: A retrospective cohort study. BMC Pregnancy Childbirth 2022, 22, 261. [Google Scholar] [CrossRef]
- Wang, Z.; Tao, X.; Liu, S.; Zhao, Y.; Yang, X. An update review on Listeria infection in pregnancy. Infect. Drug Resist. 2021, 14, 1967–1978. [Google Scholar] [CrossRef] [PubMed]
- Almeida-Santos, A.C.; Novais, C.; Peixe, L.; Freitas, A.R. Enterococcus spp. as a producer and target of bacteriocins: A double-edged sword in the antimicrobial resistance crisis context. Antibiotics 2021, 10, 1215. [Google Scholar] [CrossRef] [PubMed]
- Franz, C.M.; van Belkum, M.J.; Holzapfel, W.H.; Abriouel, H.; Gálvez, A. Diversity of enterococcal bacteriocins and their grouping in a new classification scheme. FEMS Microbiol. Rev. 2007, 31, 293–310. [Google Scholar] [CrossRef] [PubMed]
- Layton, B.A.; Walters, S.P.; Lam, L.H.; Boehm, A.B. Enterococcus species distribution among human and animal hosts using multiplex PCR. J. Appl. Microbiol. 2020, 109, 539–547. [Google Scholar] [CrossRef] [PubMed]
- Hanchi, H.; Mottawea, W.; Sebei, K.; Hammami, R. The genus Enterococcus: Between probiotic potential and safety concerns—An update. Front. Microbiol. 2018, 9, 1791. [Google Scholar] [CrossRef] [PubMed]
- Bondi, M.; Laukova, A.; de Niederhausern, S.; Messi, P.; Papadopoulou, C.; Economou, V. Controversial Aspects Displayed by Enterococci: Probiotics or Pathogens? Biomed. Res. Int. 2020, 20, 9816185. [Google Scholar] [CrossRef] [PubMed]
- Flokas, M.E.; Karageorgos, S.A.; Detsis, M.; Alevizakos, M.; Mylonakis, E. Vancomycin-resistant enterococci colonisation, risk fac-tors and risk for infection among hospitalised paediatric patients: A systematic review and meta-analysis. Int. J. Antimicrob. Agents 2017, 49, 565–572. [Google Scholar] [CrossRef]
- Martín, R.; Langa, S.; Reviriego, C.; Jiménez, E.; Marín, M.L.; Xaus, J.; Fernández, L.; Rodríguez, J.M. Human milk is a source of lactic acid bacteria for the infant gut. J. Pediatr. 2003, 143, 754–758. [Google Scholar] [CrossRef]
- Landete, J.M.; Peirotén, A.; Medina, M.; Arqués, J.L.; Rodriguez, E. Virulence and antibiotic resistance of enterococci isolated from healthy breastfed infants. Microb. Drug Resist. 2018, 24, 63–69. [Google Scholar] [CrossRef]
- Francino, M.P. Antibiotics and the human gut microbiome: Dysbioses and accumulation of resistances. Front. Microbiol. 2016, 6, 1543. [Google Scholar] [CrossRef]
- Lebreton, F.; van Schaik, W.; McGuire, M.A.; Godfrey, P.; Griggs, A.; Mazumdar, V.; Corander, J.; Cheng, L.; Saif, S.; Young, S.; et al. Emergence of epidemic multidrug-resistant Enterococcus faecium from animal and commensal strains. mBio 2013, 4, e00534-13. [Google Scholar] [CrossRef]
- Neves, J.V. Editorial for Special Issue “Alternatives to Antibiotics: Bacteriocins and Antimicrobial Peptides”. Antibiotics 2022, 11, 860. [Google Scholar] [CrossRef]
- Perez, R.H.; Zendo, T.; Sonomoto, K. Novel bacteriocins from lactic acid bacteria (LAB): Various structures and applications. Microb. Cell Fact. 2014, 13 (Suppl. 1), S3. [Google Scholar] [CrossRef]
- Cavera, V.L.; Arthur, T.D.; Kashtanov, D.; Chikindas, M.L. Bacteriocins and their position in the next wave of conventional antibiotics. Int. J. Antimicrob. Agents 2015, 46, 494–501. [Google Scholar] [CrossRef]
- Alvarez-Sieiro, P.; Montalbán-López, M.; Mu, D.; Kuipers, O.P. Bacteriocins of lactic acid bacteria: Extending the family. Appl. Microbiol. Biotechnol. 2016, 100, 2939–2951. [Google Scholar] [CrossRef]
- Cavicchioli, V.Q.; Camargo, A.C.; Todorov, S.D.; Nero, L.A. Novel bacteriocinogenic Enterococcus hirae and Pediococcus pentosaceus strains with antilisterial activity isolated from Brazilian artisanal cheese. J. Dairy Sci. 2017, 100, 2526–2535. [Google Scholar] [CrossRef]
- Moraes, P.M.; Perin, L.M.; Todorov, S.D.; Franco, S.D.; Silva, A.; Franco, B.D.G.M.; Nero, L.A. Bacteriocinogenic and virulence potential of Enterococcus isolates obtained from raw milk and cheese. J. Appl. Microbiol. 2012, 113, 318–328, Erratum in J. Appl. Microbiol. 2012, 113, 564. [Google Scholar] [CrossRef] [PubMed]
- Im, E.J.; Lee, H.H.; Kim, M.; Kim, M.K. Evaluation of enterococcal probiotic usage and review of potential health benefits, safety, and risk of antibiotic-resistant strain emergence. Antibiotics 2023, 12, 1327. [Google Scholar] [CrossRef] [PubMed]
- Fernandez, L.; Langa, S.; Martin, V.; Maldonado, A.; Jimenez, E.; Martin, R.; Rodríguez, J.M. The human milk microbiota: Origin and potential roles in health and disease. Pharmacol. Res. 2013, 69, 1–10. [Google Scholar] [CrossRef] [PubMed]
- EUCAST Disk Diffusion Method for Antimicrobial Susceptibility Testing. Version 11.0. January 2023. Available online: www.eucast.org (accessed on 19 September 2023).
- Sánchez-Hidalgo, M.; Maqueda, M.; Gálvez, A.; Abriouel, H.; Valdivia, E.; Martínez-Bueno, M. The genes coding for enterocin EJ97 production by Enterococcus faecalis EJ97 are located on a conjugative plasmid. Appl. Environ. Microbiol. 2003, 69, 1633–1641. [Google Scholar] [CrossRef] [PubMed]
- Aymerich, T.; Holo, H.; Havarstein, L.S.; Hugas, M.; Garriga, M.; Nes, I.F. Biochemical and genetic characterization of enterocin A from Enterococcus faecium, a new antilisterial bacteriocin in the pediocin family of bacteriocins. Appl. Environ. Microbiol. 1996, 62, 1676–1682. [Google Scholar] [CrossRef] [PubMed]
- Du Toit, M.; Franz, C.; Dicks, L.M.T.; Holzapfel, W.H. Preliminary characterization of bacteriocins produced by Enterococcus faecium and Enterococcus faecalis isolated from pig faeces. J. Appl. Microbiol. 2000, 88, 482–494. [Google Scholar] [CrossRef]
- Gutiérrez, J.; Criado, R.; Citti, R.; Martín, M.; Herranz, C.; Nes, I.F.; Cintas, L.M.; Hernández, P.E. Cloning, production and functional expression of enterocin P, a sec-dependent bacteriocin produced by Enterococcus faecium P13, in Escherichia coli. Int. J. Food Microbiol. 2005, 103, 239–250. [Google Scholar] [CrossRef]
- Ruiz-Rodríguez, M.; Martínez-Bueno, M.; Martín-Vivaldi, M.; Valdivia, E.; Soler, J.J. Bacteriocins with a broader antimicrobial spectrum prevail in enterococcal symbionts isolated from the hoopoe’s uropygial gland. FEMS Microbiol. Ecol. 2013, 85, 495–502. [Google Scholar] [CrossRef]
- Yousif, N.M.K.; Dawyndt, P.; Abriouel, H.; Wijaya, A.; Schillinger, U.; Vancanneyt, M.; Swings, J.; Dirar, H.A. Molecular characterization, technological properties and safety aspects of enterococci from ‘Hussuwa’, an African fermented sorghum product. J. Appl. Microbiol. 2005, 98, 216–228. [Google Scholar] [CrossRef]
- Martínez-Bueno, M.; Valdivia, E.; Gálvez, A.; Coyette, J.; Maqueda, M. Analysis of the gene cluster involved in production and immunity of the peptide antibiotic AS-48 in Enterococcus faecalis. Mol. Microbiol. 1998, 27, 347–358. [Google Scholar] [CrossRef]
- Holo, H.; Nilssen, O.; Nes, I.F. Lactococcin A, a new bacteriocin from Lactococcus lactis subsp. cremoris: Isolation and charac-terization of the protein and its gene. J. Bacteriol. 1991, 173, 3879–3887. [Google Scholar] [CrossRef]
- Baquero, F.; Lanza, V.F.; Duval, M.; Coque, T.M. Ecogenetics of antibiotic resistance in Listeria monocytogenes. Mol. Microbiol. 2020, 113, 570–579. [Google Scholar] [CrossRef] [PubMed]
- Charpentier, E.; Courvalin, P. Antibiotic resistance in Listeria spp. Antimicrob. Agents Chemother. 1999, 43, 2103–2210. [Google Scholar] [CrossRef] [PubMed]
- Poyart-Salmeron, C.; Carlier, C.; Trieu-Cuot, P.; Courtier, A.L.; Courvalin, P. Transferable plasmid-mediated antibiotic resistance in Listeria monocytogenes. Lancet 1990, 335, 1419–1426. [Google Scholar]
- Caruso, M.; Fraccalvieri, R.; Pasquali, F.; Santagada, G.; Latorre, L.M.; Difato, L.M.; Miccolupo, A.; Normanno, G.; Parisi, A. Antimicrobial susceptibility and multilocus sequence typing of Listeria monocytogenes isolated over 11 years from food, humans, and the environment in Italy. Foodborne Pathog. Dis. 2020, 17, 284–294. [Google Scholar] [CrossRef] [PubMed]
- Vicente, M.F.; Perez-Díaz, J.C.; Baquero, F.; de Pedro, M.A.; Berenguer, J. Penicillin-binding protein 3 of Listeria monocytogenes as the primary lethal target for beta-lactams. Antimicrob. Agents Chemother. 1990, 34, 539–542. [Google Scholar] [CrossRef]
- Mata, M.T.; Baquero, F.; Perez-Diaz, J.C. A multidrug efflux transporter in Listeria monocytogenes. FEMS Microbiol. Lett. 2000, 187, 185–188. [Google Scholar] [CrossRef]
- De Vuyst, L.; Moreno, M.F.; Revets, H. Screening for enterocins and detection of hemolysin and vancomycin resistance in enterococci of different origins. Int. J. Food Microbiol. 2003, 84, 299–318. [Google Scholar] [CrossRef]
- Pangallo, D.; Harichová, J.; Karelová, E.; Drahovská, H.; Chovanová, K.; Ferianc, P.; Timko, J. Molecular investigation of enterococci isolated from different environmental sources. Biologia 2004, 59, 829–837. [Google Scholar]
- Özdemir, G.B.; Oryasm, E.; Biyik, H.H.; Özteber, M.; Bozdoğan, B. Phenotypic and genotypic characterization of bacteriocins in enterococcal isolates of different sources. Ind. J. Microbiol. 2011, 51, 182–187. [Google Scholar] [CrossRef]
- Poeta, P.; Costa, D.; Rojo-Bezares, B.; Zarazaga, M.; Klibi, N.; Rodrigues, J.; Torres, C. Detection of antimicrobial activities and bacteriocin structural genes in faecal enterococci of wild animals. Microbiol. Res. 2007, 162, 257–263. [Google Scholar] [CrossRef]
- Casaus, F.; Nilsen, T.; Cintas, L.M.; Nes, L.F.; Hernández, P.E.; Holo, H. Enterocin B, a new bacteriocin from Enterococcus faecium TI36 which can act synergistically with enterocin A. Microbiology 1997, 143, 2287–2294. [Google Scholar] [CrossRef]
- Franz, C.M.A.P.; Worobo, R.W.W.; Quadri, L.E.N.; Schillinger, U.; Holzapfel, W.H.; Vederas, J.C.; Stiles, M.E. Atypical genetic locus associated with constitutive production of enterocin B by Enterococcus faecium BFE 900. Appl. Environ. Microbiol. 1999, 65, 2170–2178. [Google Scholar] [CrossRef] [PubMed]
- Foulquié Moreno, M.R.; Callewaert, R.; Devreese, B.; Van Beeumen, J.; De Vuyst, L. Isolation and biochemical characterisation of enterocins produced by enterococci from different sources. J. Appl. Microbiol. 2003, 94, 214–229. [Google Scholar] [CrossRef] [PubMed]
- Arqués, J.L.; Rodríguez, E.; Langa, S.; Landete, J.M.; Medina, M. Antimicrobial activity of lactic acid bacteria in dairy products and gut: Effect on pathogens. Biomed. Res. Int. 2015, 2015, 584183. [Google Scholar] [CrossRef] [PubMed]
- Ogaki, M.B.; Rocha, K.R.; Terra, M.R.; Furlaneto, M.C.; Furlaneto-Maia, L. Screening of the enterocin-encoding genes and antimicrobial activity in Enterococcus species. J. Microbiol. Biotechnol. 2016, 26, 1026–1034. [Google Scholar] [CrossRef] [PubMed]
- Darbandi, A.; Asadi, A.; Ari, M.M.; Ohadi, E.; Talebi, M.; Zadeh, M.H.; Emamie, A.D.; Ghanavati, R.; Kakanj, M. Bacteriocins: Properties and potential use as antimicrobials. J. Clin. Lab. Anal. 2022, 36, 24093. [Google Scholar] [CrossRef] [PubMed]
- Wu, Y.; Pang, X.; Wu, Y.; Liu, X.; Zhang, X. Enterocins: Classification, Synthesis, Antibacterial Mechanisms and Food Applications. Molecules 2022, 27, 2258. [Google Scholar] [CrossRef]
- Zdolec, N.; Kiš, M. Antimicrobial properties of food enterococci. In Lactic Acid Bacteria in Food Biotechnology; Innovations and Functional Aspects; Ray, R.C., Paramithiotis, P., Azevedo, V.A.C., Montet, D., Eds.; Elsevier: Amsterdam, The Netherlands, 2022; Volume 11, pp. 195–203. [Google Scholar] [CrossRef]
- Umu, Ö.C.O.; Bäuerl, C.; Oostindjer, M.; Pope, P.B.; Hernández, P.E.; Pérez-Martínez, G.; Diep, D.B. The potential of class II bacteriocins to modify gut microbiota to improve host health. PLoS ONE 2016, 11, e0164036. [Google Scholar] [CrossRef]
- Dobson, A.; Cotter, P.D.; Ross, R.P.; Hill, C. Bacteriocin production: A probiotic trait? Appl. Environ. Microbiol. 2012, 78, 1–6. [Google Scholar] [CrossRef]
- Ramirez, J.; Guarner, F.; Bustos Fernandez, L.; Maruy, A.; Sdepanian, V.L.; Cohen, H. Antibiotics as major disruptors of gut microbiota. Front. Cell. Infect. Microbiol. 2020, 10, 572912. [Google Scholar] [CrossRef]
- McDonnell, L.; Gilkes, A.; Ashworth, M.; Rowland, V.; Harries, T.H.; Armstrong, D.; White, P. Association between antibiotics and gut microbiome dysbiosis in children: Systematic review and meta-analysis. Gut Microbes 2021, 13, 1. [Google Scholar] [CrossRef] [PubMed]
- Franz, C.M.A.P.; Huch, M.; Abriouel, H.; Holzapfel, W.; Gálvez, A. Enterococci as probiotics and their implications in food safety. Int. J. Food Microbiol. 2011, 151, 125–140. [Google Scholar] [CrossRef]
- Giraffa, G. Functionality of enterococci in dairy products. Int. J. Food Microbiol. 2003, 88, 215–222. [Google Scholar] [CrossRef]
- Dapkevicius, M.d.L.E.; Sgardioli, B.; Câmara, S.P.A.; Poeta, P.; Malcata, F.X. Current Trends of Enterococci in Dairy Products: A Comprehensive Review of Their Multiple Roles. Foods 2021, 10, 821. [Google Scholar] [CrossRef]
- Eijsink, V.G.; Axelsson, L.D.; Diep, B.; Håvarstein, L.S.; Holo, H.; Nes, I.F. Production of class II bacteriocins by lactic acid bacteria; an example of biological warfare and communication. Antonie Leeuwenhoek 2002, 81, 639–654. [Google Scholar] [CrossRef] [PubMed]
- Gensollen, T.; Iyer, S.S.; Kasper, D.L.; Blumberg, R.S. How colonization by microbiota in early life shapes the immune system. Science 2016, 352, 539–544. [Google Scholar] [CrossRef] [PubMed]
- He, Y.; Yang, Q.; Tian, L.; Zhang, Z.; Qiu, L.; Tao, X.; Wei, H. Protection of surface layer protein from Enterococcus faecium WEFA23 against Listeria monocytogenes CMCC54007 infection by modulating intestinal permeability and immunity. Appl. Microbiol. Biotechnol. 2021, 105, 4269–4284. [Google Scholar] [CrossRef] [PubMed]
- Popović, N.; Djokić, J.; Brdarić, E.; Dinić, M.; Terzić-Vidojević, A.; Golić, N.; Veljović, K. The influence of heat-killed Enterococcus faecium BGPAS1-3 on the tight junction protein expression and immune function in differentiated Caco-2 cells infected with Listeria monocytogenes ATCC 19111. Front. Microbiol. 2019, 10, 412. [Google Scholar] [CrossRef] [PubMed]
- Rajput, K.; Dubey, R.C.; Kumar, A. Probiotic potential and immunomodulatory properties in Enterococcus faecium GMB24 and Enterococcus hirae SMB16 isolated from goat and sheep milk. Arch. Microbiol. 2022, 204, 619. [Google Scholar] [CrossRef]
- Salvucci, E.; Saavedra, L.; Hebert, E.M.; Haro, C.; Sesma, F. Enterocin CRL35 inhibits Listeria monocytogenes in a murine model. Foodborne Pathog. Dis. 2012, 9, 68–74. [Google Scholar] [CrossRef]
- Song, M.W.; Kim, K.-T.; Paik, H.-D. Probiotics as a functional health supplement in infant formulas for the improvement of intestinal microflora and immunity. Food Rev. Int. 2021, 39, 858–874. [Google Scholar] [CrossRef]
Disclaimer/Publisher’s Note: The statements, opinions and data contained in all publications are solely those of the individual author(s) and contributor(s) and not of MDPI and/or the editor(s). MDPI and/or the editor(s) disclaim responsibility for any injury to people or property resulting from any ideas, methods, instructions or products referred to in the content. |
© 2024 by the authors. Licensee MDPI, Basel, Switzerland. This article is an open access article distributed under the terms and conditions of the Creative Commons Attribution (CC BY) license (https://creativecommons.org/licenses/by/4.0/).